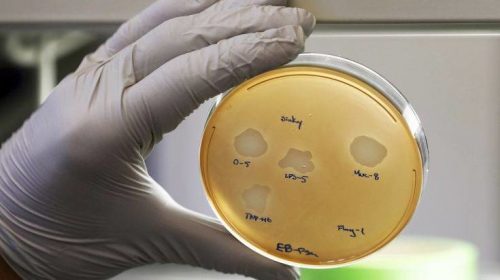

Ποιες είναι οι εφαρμογές στις οποίες μπορεί να αξιοποιηθεί στο μέλλον
Το πρώτο γονιδίωμα βακτηρίου, που δημιουργήθηκε αποκλειστικά από υπολογιστή, παρουσίασαν επιστήμονες στην Ελβετία. Παρόλο όμως που το γονιδίωμα του οργανισμού με την ονομασία C.ethensis-2.0 παρήχθη με τη μορφή ενός πολύ μεγάλου μορίου DNA, ο ίδιος ο μικροοργανισμός δεν υπάρχει ακόμη.
Παρά ταύτα, η βάση δεδομένων του Εθνικού Κέντρου Πληροφοριών Βιοτεχνολογίας των ΗΠΑ, στην οποία είναι αποθηκευμένα όλα τα γονιδιώματα των γνωστών έμβιων οργανισμών του κόσμου, περιλαμβάνει πλέον και το γονιδίωμα του Caulobacter ethensis-2.0.
Το εν λόγω συνθετικό γονιδίωμα βασίζεται στο γονιδίωμα ενός καλά μελετημένου και αβλαβούς βακτηρίου του γλυκού νερού, του Caulobacter crescentus, που συναντάται σε πηγές, ποτάμια και λίμνες όλου του κόσμου, χωρίς να είναι παθογόνο. Το γονιδίωμα του περιέχει 4.000 γονίδια και από αυτά μόνο τα 680 είναι απολύτως αναγκαία για την επιβίωση του (τουλάχιστον σε συνθήκες εργαστηρίου).
Οι ερευνητές του Ελβετικού Ομοσπονδιακού Ινστιτούτου Τεχνολογίας Ζυρίχης (ΕΤΗ), με επικεφαλής τον καθηγητή πειραματικής βιολογίας συστημάτων Μπιτ Κρίστεν, που έκαναν τη σχετική δημοσίευση στο περιοδικό της Εθνικής Ακαδημίας Επιστημών των ΗΠΑ (PNAS), χρησιμοποίησαν αυτά τα 680 απολύτως ζωτικά γονίδια του Caulobacter crescentus ως αφετηρία για να συνθέσουν στη συνέχεια εξ αρχής το γονιδίωμα ενός άλλου μικροοργανισμού, με τη βοήθεια ενός αλγόριθμου υπολογιστή που ανέπτυξαν οι ίδιοι.
Το νέο γονιδίωμα του Caulobacter ethensis-2.0 συνδυάζει το αρχικό γονιδίωμα του Caulobacter crescentus με τμήματα ενός νέου τεχνητού γονιδιώματος. Η όλη διαδικασία απαίτησε ένα έτος περίπου και είχε κόστος μόνο 120.000 ελβετικών φράγκων, έναντι δέκα ετών και κόστους 40 εκατομμυρίων δολαρίων για να δημιουργηθεί το πρώτο βακτηριακό γονιδίωμα από τον Αμερικανό πρωτοπόρο Κρεγκ Βέντερ πριν 11 χρόνια.
«Μέσω του αλγόριθμου μας ξαναγράψαμε τελείως το γονιδίωμα (σ.σ. του Caulobacter crescentus) σε μια νέα αλληλουχία γραμμάτων DNA, που δε μοιάζει πλέον καθόλου με την αρχική αλληλουχία, αν και η βιολογική λειτουργία σε επίπεδο πρωτεϊνών παραμένει η ίδια», δήλωσε ο Κρίστεν. «Πιστεύουμε ότι σύντομα θα είμαστε σε θέση να παράγουμε λειτουργικά βακτηριακά κύτταρα από ένα τέτοιο γονιδίωμα», πρόσθεσε, όπως αναφέρει το Αθηναϊκό Πρακτορείο Ειδήσεων.
Κάτι τέτοιο θα ανοίξει το δρόμο για την μελλοντική αξιοποίηση των συνθετικών μικροοργανισμών σε μια πληθώρα εφαρμογών βιοτεχνολογίας, π.χ. για την παραγωγή πολύπλοκων φαρμακευτικών μορίων, βιταμινών, εμβολίων DNA κ.ά.
Δεν είναι ακόμη σαφές πότε θα καταστεί εφικτό να παραχθεί το πρώτο συνθετικό βακτήριο με πλήρως τεχνητό γονιδίωμα. Ο Κρίστεν τόνισε ότι «όσο πολλά υποσχόμενη είναι μια τέτοια έρευνα και όσες δυνητικές εφαρμογές έχει, απαιτείται επίσης μια βαθιά συζήτηση στην κοινωνία για τους στόχους αυτής της τεχνολογίας και ταυτόχρονα για το πώς θα αποφευχθούν οι καταχρήσεις της».
ΑΞΙΟΛΟΓΗΣΤΕ ΤΟ ΑΡΘΡΟ